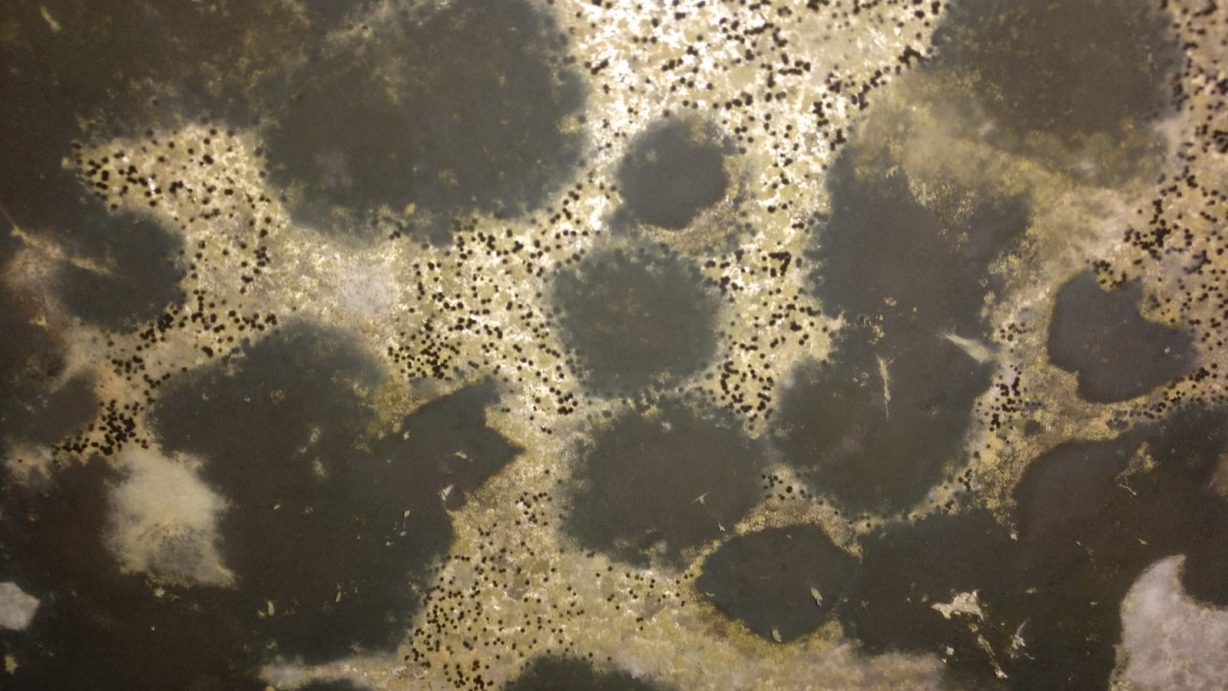
como eliminar mohos de una pared

Si tiene problemas con las plagas en Madrid, BIO-UNIT-CONTROL, como empresa de control de control de plagas en Madrid, queremos poner todos los servicios que ofrecemos al alcance de todos. Por este motivo, estamos intentando mejorar nuestros servicios ofreciendo una oferta a todos nuestros clientes. Como bien sabéis, nos dedicamos a resolver vuestros problemas de […]
Empresa desinsectación de cucarachas
Empresa desinsectación de cucarachas Las cucarachas son una de las plagas más problemáticas y desagradables que pueden invadir nuestro hogar, oficina o negocio. No solo representan un riesgo para la higiene y la estética, sino que también pueden ser responsables de diversos problemas de salud, entre los que se incluyen gastritis, disentería, salmonelosis y problemas […]
Cómo deshacerse de las cucarachas en casa
Cómo deshacerse de las cucarachas en casa no es tarea sencilla. Las cucarachas tienen una gran capacidad de esconderse y gran instinto de supervivencia, por lo que puede ser verdaderamente una situacion preocupante si no tienes la ayuda de una empresa de control de plagas. Las empresas especializadas en eliminar cucarachas en Madrid te pueden […]
Cómo afectan las palomas.
Las palomas no solo afectan a nuestra salud, sino que también influyen en la salud de nuestro edificio. Como afectan las palomas. Respecto a como afectan las palomas a nuestra salud, debemos reiterar, como ya hemos dicho en alguna ocasión, que son portadoras de enfermedades, que son portadoras de parasito como las garrapatas y que […]
Qué hacer si tienes ratas en casa
Como respuesta a la pregunta de ¿Qué hacer si tienes ratas en casa?, podemos decir que, si han detectado la presencia de ratas en su vivienda o local, lo mas importante es mantener la calma. Primeramente, es localizar o ubicar en donde se encuentra, si es una zona o habitación que tenga puerta, lo mas […]
Cómo eliminar moho de una pared
Antes de explicar cómo eliminar moho de una pared debemos tener claro los factores que pueden favorecer el crecimiento de moho en nuestra vivienda. Principalmente este crecimiento pude ser debido a la falta de ventilación o movimiento de aire dentro de nuestra vivienda, humedad ambiental que junto con temperaturas cálidas son unos de los factores […]